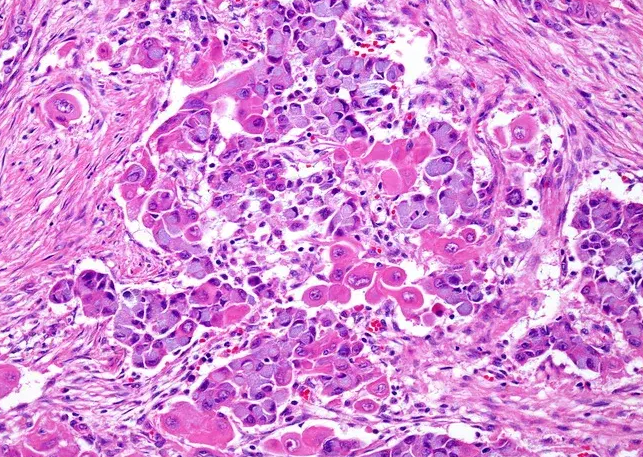
Mucinous cells with blue cytoplasm and flattened nuclei, intermixed with squamous cells containing dense eosinophilic cytoplasm and round nuclei. Courtesy Dr. V. Penopoulos.

Head & Neck
Κεφαλή & Τράχηλος
35 images

Mucinous cells with blue cytoplasm and flattened nuclei, intermixed with squamous cells containing dense eosinophilic cytoplasm and round nuclei. Courtesy Dr. V. Penopoulos.
Mucinous cells with blue cytoplasm and flattened nuclei, intermixed with squamous cells containing dense eosinophilic cytoplasm and round nuclei. Courtesy Dr. V. Penopoulos.

Mucinous cells with blue cytoplasm and flattened nuclei, intermixed with squamous cells containing dense eosinophilic cytoplasm and round nuclei. Courtesy Dr. V. Penopoulos.

Mucinous cells with blue cytoplasm and flattened nuclei, intermixed with squamous cells containing dense eosinophilic cytoplasm and round nuclei. Courtesy Dr. V. Penopoulos.

Gross examination of the excised cyst reveals a smooth surface lining of uniform thickness without papillary projections (Courtesy Dr. V. Penopoulos)

Gross examination of the excised cyst reveals a smooth surface lining of uniform thickness without papillary projections (Courtesy Dr. V. Penopoulos)

Gross examination of the excised cyst reveals a smooth surface lining of uniform thickness without papillary projections (Courtesy Dr. V. Penopoulos)

Thyroglossal duct cysts. Neck MRI – Detailed imaging of the cyst. Courtesy Dr. V. Penopoulos.

Thyroglossal duct cysts. Neck MRI – Detailed imaging of the cyst. Courtesy Dr. V. Penopoulos.

Thyroglossal duct cysts. Neck MRI – Detailed imaging of the cyst. Courtesy Dr. V. Penopoulos.

Thyroglossal duct cysts. Neck MRI – Detailed imaging of the cyst. Courtesy Dr. V. Penopoulos.

Thyroglossal duct cysts. Neck MRI – Detailed imaging of the cyst. Courtesy Dr. V. Penopoulos.

Thyroglossal duct cysts. Neck MRI – Detailed imaging of the cyst. Courtesy Dr. V. Penopoulos.

Thyroglossal duct cysts. Neck MRI – Detailed imaging of the cyst. Courtesy Dr. V. Penopoulos.

Thyroglossal duct cysts. Neck MRI – Detailed imaging of the cyst. Courtesy Dr. V. Penopoulos.



















